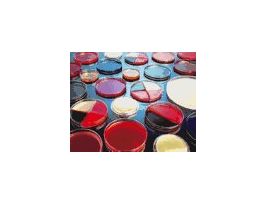
Prepared agar plate, PDA (potato dextrose agar), 10/pk
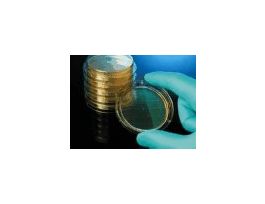
Contact plate, TSA with Lecithin and Tween 80, 10/pk

Need Help?
800-229-7252
Lab Chemicals

-

-

-

-

-

-
-

-

-
 Prepared media tube, D/E neutralizing broth10 mL prepared tube, 20 packEW-14203-64CPEW-14203-64-PK
Prepared media tube, D/E neutralizing broth10 mL prepared tube, 20 packEW-14203-64CPEW-14203-64-PK -

-

-

-

-